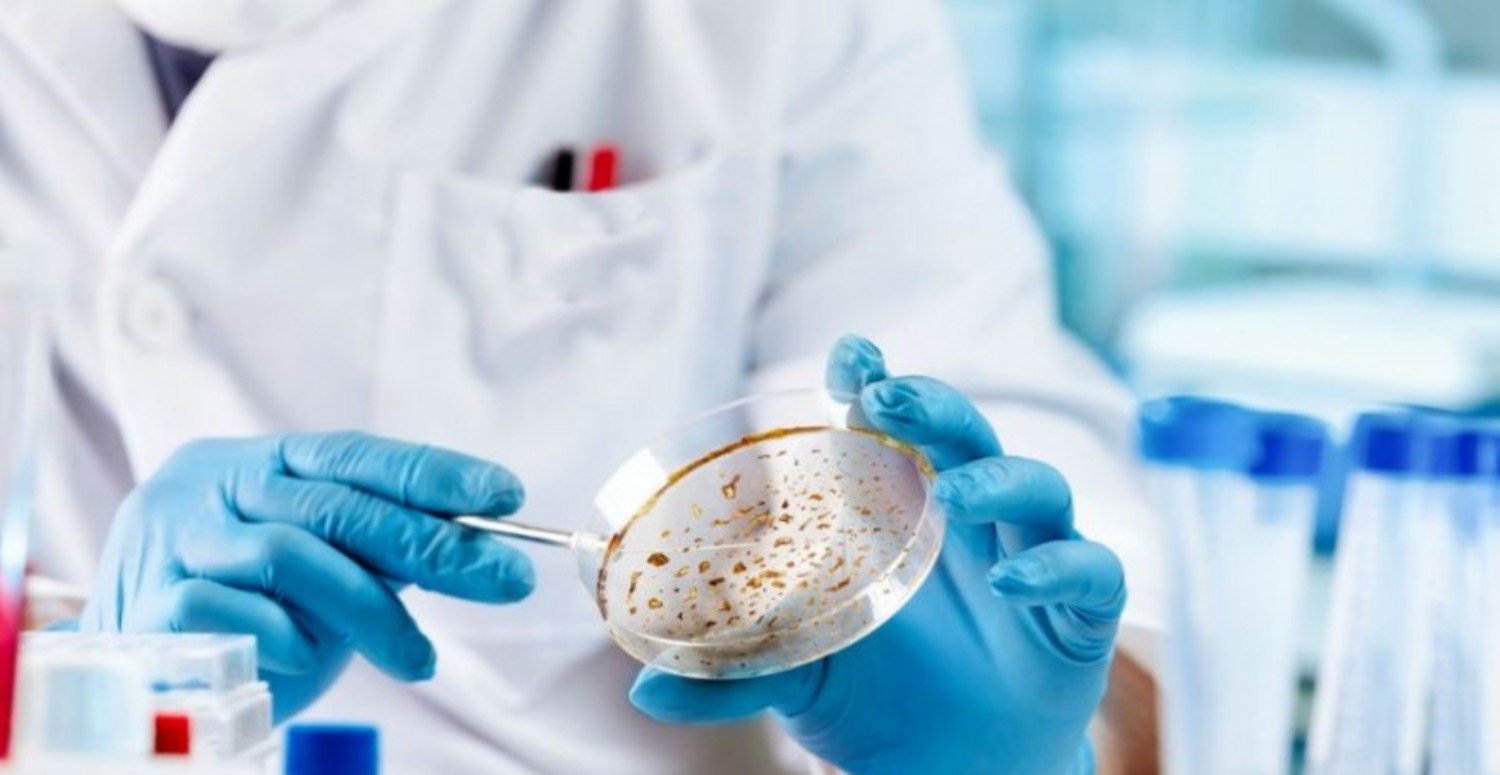
ALASKAPOX VİRÜSÜ HAKKINDA

Alaska’da yaşayan yaşlı bir adam, Alaskapox’a yakalandıktan sonra ölen ilk kişi olarak kayıtlara geçti. Bu virüs, daha önce sadece küçük memeliler arasında bulaşan ve insanlara nadiren geçen bir hastalık olarak biliniyordu. Virüsün belirtileri arasında cilt lezyonları, şişmiş lenf düğümleri ve kas ağrısı bulunuyor. Peki Alaskapox virüsü nedir, nasıl bulaşır ve tedavi edilir? Haberimizde...
ALASKAPOX VİRÜSÜ NEDİR?
Alaskapox virüsü, 2015 yılında Alaska’da keşfedilen bir ortopoksvirüs türüdür. Bu virüsler, çiçek, maymun çiçeği ve inek çiçeği gibi tehlikeli hastalıklara neden olan virüslerle akrabadır.

Alaskapox virüsü, kızıl sırtlı fareler ve sivri fareler gibi küçük memelilerde yaygın olarak bulunur. İnsanlara bulaştığında ise genellikle hafif seyreden bir hastalık oluşturur.
ALASKAPOX VİRÜSÜ NASIL BULAŞIR?
Alaskapox virüsünün insanlara nasıl bulaştığı tam olarak bilinmemektedir. Ancak, virüsle enfekte olmuş hayvanlarla temas etmenin bir risk faktörü olduğu düşünülmektedir.

Örneğin, ölen adamın kendisini sokan bir sokak kedisinden virüsü aldığını söylediği belirtildi. Alaskapox virüsünün insanlar arasında bulaşmadığına dair kanıt bulunmaktadır.
ALASKAPOX VİRÜSÜ NASIL TEDAVİ EDİLİR?
Alaskapox virüsüne karşı etkili bir aşı veya ilaç henüz geliştirilmemiştir. Hastalığın tedavisi, semptomların şiddetine göre değişir. Bazı hastalar, cilt lezyonlarının iyileşmesini beklerken, diğerleri ağrı kesici veya antibiyotik gibi ilaçlara ihtiyaç duyabilir. Ciddi vakalarda, hastaneye yatış ve yoğun bakım gerekebilir.
Alaskapox virüsü, yeni keşfedilen ve potansiyel olarak ölümcül bir hastalıktır. Alaska’da yaşayan yaşlı bir adam, bu virüse bağlı olarak hayatını kaybeden ilk kişi oldu. Virüsün küresel bir salgına yol açıp açmayacağı henüz bilinmemektedir. Ancak, sağlık yetkilileri, virüsün yayılmasını önlemek için hayvanlarla teması sınırlamak ve cilt yaralarına dikkat etmek gibi önlemler alınmasını tavsiye etmektedir




